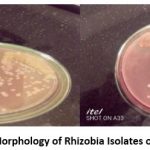

Introduction
The conversation of N2 gas into ammonia by a biological nitrogen fixation has significant meaning in improving soil productiveness, health, and yield of crops.
The nitrogen-fixing system in general offers an economically attractive and ecologically all-encompassing means of decreasing none environmentally friendly inputs and enhancing internal resources like nitrogen and organic matter content of the soil.
It also improves soil health by supporting the progression of other beneficial soil microorganisms such as fungi, actinomycetes, and bacteria if the roots of the legumes are left in the ground. Symbiotic nitrogen fixation; between legumes and Rhizobium, is a major source of nitrogen to the ecosystem (FAO, 2016). Symbiotic nitrogen fixation permits the host plant to grow well providing important nutrients like ammonia or amino acids in the absence of nitrogen fertilizer. Yet, it may be essential to apply phosphorus (P) and other deficient nutrients. In the association, the legumes also benefited substances like organic acids as a carbon and energy source (Mitiku and Mnalku, 2019). Legumes like faba bean play a major part in enhancing the income of poor farmers by serving as food, feed, and at the same time, it also plays a major part in enhancing soil fertility.
In terms of faba bean production, Ethiopia positions second next to China and fourth next to France, Australia, and the United Kingdom in terms of export in respective order (FAO, 2016). Faba bean takes the first portion in terms of area (466,698 ha) and production (172739.9 tones) of crop legumes grown in Ethiopia (CSA, 2019/20). The mean domestic yield of faba beans in Ethiopia is about 2.1 t ha-1 (CSA, 2018) which is small in parallel to the domestic mean grain yield of 3.7 t ha-1 in major producer countries (FAOSTAT, 2017). This low yield of faba bean production in Ethiopia is typically linked to various biotic and abiotic influences like the deficiency of effective rhizobia in the soil, recurrent disease occurrence, parasitic weeds, soil acidity, and fertility decline could be mentioned (Aynabeba et al. 2001and Mnalku et al. 2009). Controlling yield-limiting factors mentioned above, finding effective isolates of rhizobia, and inoculating faba bean can curve low productivity of the crop where there are signs of yield declining and nitrogen deficiency symptoms (FAOSTAT, 2010). In Ethiopia, there are encouraging signs of research works in developing elite rhizobial isolates. However, only a few studies have been done on finding symbiotically efficient faba bean nodulating rhizobial isolates at the Eastern Hararghe highlands of Ethiopia. Thus, this study was carried out aiming to find symbiotically efficiency of faba bean nodulating rhizobial isolates around Eastern Hararghe highlands of Ethiopia.
Materials and Methods
Description of the Study Area
Rhizobia were isolated from soils of faba bean growing areas in eastern Hararghe highlands of Ethiopia through a host trap method. These soil sampling areas did not have any inoculation history. The soil sampling districts namely; Bedeno, Deder and Kurfa Chele are located at 9.1143° N, 41.6336° E at an altitude of 1200 to 3100 m above sea level, 9.3219° N, 41.4463° E at an altitude of 1200 to 3140 m above sea level and 9.2359° N, 41.8228° E at an altitude of 1400 to 3400 m above sea level, respectively. In this area there are two main showery seasons, the shorter showery season (Belg) prolongs from April to June and accounts for about 25 percent of the annual rainfall, whereas the longer showery season (Meher) extends from July to October and accounts for about 45 percent (Belay et al., 1998). Regosols, Cambisols, and Fluvisols and their association are the major soil types found in these districts.
Study Design
The pot experiments were laid down in randomized complete block design (RCBD) with three replications in a greenhouse; for the authentication trial as control, each block contained two pots, negative control with no KNO3, no inoculum, and positive control with 0.05% KNO3, absence of inoculum.
Soil Sample Collection
The soil samples were collected from three woredas (districts) of eastern Hararghe highlands around Bedeno, Deder, and Kurfa Cheleof Ethiopia in April 2011. In each area, four bulk soil samples were randomly collected from a depth of 30 cm to trap wild faba bean nodulating rhizobia (Somasegaran and Hoben, 1994). GPS was used for referring to the soil sampling areas.
Isolation of Rhizobia
Five seeds of faba bean (Moti variety) were sown for each bulk sample in a sterile plastic pot at Haramya University greenhouse. The pots were watered every three days for 45 days. After 45 days, pink, red, or brown nodules were collected and transported to the Haramya University Microbiology laboratory using vials containing silica gel. The nodules were thoroughly washed with distilled water to remove gross surface contamination.
After overnight soaking in distilled water, the nodules were immersed, in 95% ethanol for 10 seconds to break the surface tension and to remove air bubbles from the tissue and transferred to 3% (v/v) solution of sodium hypochlorite, and soak for 4 min (Somasegaran and Hoben, 1994).
Surface sterilized nodules were washed at least 10 times by sterile water to remove the contaminants completely. The nodules were placed in 0.1N NaCl solution and a few drops of distilled sterile water and crushed with a sterile glass rod. The suspension was then streaked on YEMA (Yeast Extract Mannitol Agar) and incubated at 28oC for 3 to 5 days. At the end of incubation 50 conspicuous colonies were collected.
Purification and Preservation of the Isolates
All isolates were tested for possible purity by undertaking colony morphology test, gram staining test, and by growing them on peptone glucose agar (PGA) and YEMA medium containing 25 ppm (0.0025%) of Congo red (YEMA-CR). The isolates were also inoculated on YEMA containing 25 g ml-1 bromothymol blue which serves as useful criteria for distinguishing the two aligned genera Rhizobium and Bradyrhizobium. The isolates were preserved on YEMA slants containing 0.3% (w/v) CaCO3 in a slant culture and stored at 4 0C for future use (Somasegaran and Hoben, 1994).
Designation of the Isolates
Each isolate was designated as EHHFR (Eastern Hararghe Highlands Faba bean Rhizobium) followed by a number (represent Kebele) and a letter (represent Village).
Determination of Salt and pH Tolerance
The in vitro pH and salt tolerance among Rhizobium isolates was determined using the method described by Lupwayi and Haque (1994). Media plates of YEMA containing various concentrations (2%, 4%, 6%, 8%, 9%, 10% &11%) of sodium chloride. For pH tolerance, TY agar media adjusted to pH levels of 4-10.5 were prepared and inoculated with appropriately diluted pure cultures of the isolates. The plates were then incubated at 30oC for four days. Finally, the growth of the rhizobial strains was qualitatively evaluated as negative (-) for no growth and positive (+) for growth, and in the same manner the susceptibility to NaCl was recorded as a positive (+) for growth or negative (-) for the absence of growth.
Authentication and Determination of Symbiotic Efficiency of Faba Bean Nodulating Rhizobia on Sterilized Sand Culture
Forty pure isolates that qualified for the presumptive test were further tested for authentication in Haramaya University greenhouse. Fine graded river sand was washed in tap water and immersed in concentrated sulfuric acid (H2 SO4) for two days.
It was washed in several changes of tap and distilled water to get rid of the last traces of the acid and autoclaved for 1.5 hours before filling into plastic pots of 3 kg volume which were surface sterilized with 95% ethanol (Lupwayi and Haque, 1994). Two hundred fifty faba bean seeds, Motie variety, of uniform size and color were surface sterilized by suspending for 10 minutes in 3-5% H2O2 with washings of several changes of distilled water (Lupwayi and Haque, 1994). The sterilized seeds were then transferred to distilled water and incubated at 25oC for 3 days of germination.
Five surface sterilized and pre-germinated seedlings were transferred into each pot, which was later thinned to three after a week of planting. Each seedling was inoculated with 1ml culture of each isolate adjusted to an inoculum size of 109 cell ml-1. The pots with seedlings were subsequently supplied with distilled water every two days and fertilized once a week with a quarter strength of Broughton and Dilworth N-free medium described in Somasegaran and Hoben (1994).
Determination of Symbiotic Efficiency of Selected Faba Bean Nodulating Rhizobia on Unsterilized Soil
The symbiotic efficiency of seven selected isolates that have symbiotic effectiveness (%) above 100 was determined in the pot experiment using unsterilized soil at Haramaya University greenhouse. The soil was well mixed, sieved, and air-dried. Three kilograms of this soil was distributed to plastic pots. Thirty-five faba bean of “Moti Variety” was surface sterilized as before and rinsed in five changes of sterile distilled water. Five un-germinated seeds were sown in each pot and later thinned down to three after germination for one week. After a week, each seedling was inoculated with 1 ml of each isolate grown for 72 h in YEM broth. The experiment was set up in replicates in the greenhouse and the pots were arranged in complete random design with each block consisting of negative control (without nitrogen and inoculum) and positive control (without inoculum but with nitrogen). The nitrogen fertilizer (KNO3) was given at a concentration of 0.5 g L-1 per week until the plants were harvested. All the pots were watered every two days.
Plant Total Nitrogen Content Analysis
The modified Kjeldahl method was used to evaluate the nitrogen content of the plant samples. In this method, plant samples were first ground, and initially, 0.3 g of the resulting material was measured in a 100 ml digestion tube for analysis.
Following this, 0.5 g of a mixture of 10 g K2SO4, 2 g CuSO4.5H2O, and 0.2 g Selenium was added to the ground sample and used as a catalyst. A mixture of sulfuric and salicylic acid (7 ml) was also added to the ground sample and permitted to react for 30 minutes. Also, 0.5 g of Na2S2O3.5H2O was added and shaken to react for five more minutes. A blank consisting of 0.5 g salt mixture and 7 ml of the sulfuric-salicylic mixture was also prepared. The digestion of the ground sample was undertaken at a temperature of 3000C for 2 h until the content turned colorless. Then, the sample was distilled by adding 75 ml of 40% NaOH and its nitrogen collected with a flask containing 20 ml boric acid until the volume reached 110 ml. Ultimately, the distillate was titrated using 0.1 N H2SO4, and the reading of the burette used to calculate the percentage nitrogen using the formula:
![]()
Where a1 = ml of titrant used for the sample
b2 = ml of titrant used for the blank
N= Normality for the acid
S = weight of the plant material
Total N uptake was calculated as
![]()
Forty-five days after sowing, the plants were collected and their roots were scored for nodulation. The shoots of plants, as well as the nodules, were then oven-dried to determine their dry weight at 70oC for 48 h at Haramaya University Microbiology laboratory. Symbiotic effectiveness (SE) of the isolates was calculated according to the equation:
![]()
Then, symbiotic efficacy (SE) of isolates were rated as ineffective, lowly-effective, effective, and highly effective, when the calculated values were <35%, 35-50%, 50-80%, and >80 %, respectively (Beck et al., 1993).
Data Analysis
Contrast among treatments was examined using one-way ANOVA (Fisher’s LSD tests) (SAS.9.2). The data that used in the analysis were nodule number, nodule dry weight, shoot dry weight, plant total nitrogen (%), and N-content.
Results and Discussion
Isolation and Presumptive Test for Identification of Rhizobia
A total of 50 isolates were obtained from soil samples of three Woredas (districts) of the eastern Hararghe highlands of Ethiopia using the host trap method. Out of these 50 isolates, only40 of them were presumptively identified as rhizobia. All of the presumptively identified rhizobia were found to be gram-negative, rod-shaped bacteria that did not absorb Congo red on YEMA-CR medium and were not grown on Peptone Glucose Agar (Somasegaran and Hoben, 1994). All of them turned Yeast Extract Mannitol Agar medium containing bromothymol blue (YEMA-BTB) into moderately yellow, yellow, and deep yellow color after 48 hours of incubation; showing that all the isolates were fast-growing acid-producing rhizobia (Gupta, 2000). Similar to this, Aynabeba et al. (2001) and Mnalku et al. (2009) also showed that all presumptively identified faba bean nodulating rhizobia were fast-growing acid-producing (Figure 1).
|
Figure 1: Colony Morphology of Rhizobia Isolates on YEMA-CR Media. |
Authentication of Rhizobia
The isolates that passed the preliminary screening test were re-inoculated to the host plant grown on sterile sand in serialized pots. Out of the 40 presumptively identified faba bean rhizobia, only 31 (10 isolates from Bedeno, 11 isolates from Deder, and 10 isolates from Kurfa Chele) were formed nodules and authenticated as true faba bean root nodulating bacteria (Vincent, 1970). The remaining 10 were other rhizosphere soil contaminants (Johnston Johnston and Beringer, 1976). In line with this, Aynabeba et al. (2001) and Argaw (2012) indicated that except few almost all of the presumptively identified faba bean rhizobia were authenticated as root nodule bacteria.
Salt and pH Tolerance
The isolates displayed growth differences on the YEMA medium adjusted to different NaCl concentrations (Table 1). Among the 31 isolates, 29 (67.7%), 31 (100%), 31 (100%), 31 (100%), 26 (83.9%) and 4 (12.9%) were grown at 2.5%, 3%, 4%, 5%, 5.5%and 6% of NaCl on YEMA medium, respectively. The most salt-tolerant isolates were EHHFR4D from Deder that grown from the lowest NaCl concentration (2.5%) to the highest salt concentration (6%) (Table 1). In the same way, Hungria and Vargas (2000) reported that usually, fast-growing rhizobia grew well between 3-5% concentrations of NaCl.
Table 1: Tolerance of the Isolates to Different Salt Concentrations.
| Sampling woredas (Districts) |
Isolates | NaCl concentration (%) | Salt Tolerance Range |
|||||
| 2.5% | 3% | 4% | 5% | 5.5% | 6% | |||
| Bedeno | EHHFR 1A | – | + | + | + | + | – | 3-5.5 |
| EHHFR 1B | + | + | + | + | + | – | 2.5-5.5 | |
| EHHFR1C | + | + | + | + | + | – | 2.5-5.5 | |
| EHHFR1D | + | + | + | + | + | – | 2.5-5.5 | |
| EHHFR2A | + | + | + | + | + | – | 2.5-5.5 | |
| EHHFR2B | + | + | + | + | + | – | 2.5-5.5 | |
| EHHFR2C | + | + | + | + | + | – | 2.5-5.5 | |
| EHHFR2D | + | + | + | + | + | – | 2.5-5.5 | |
| EHHFR3A | + | + | + | + | + | – | 2.5-5.5 | |
| EHHFR3B | + | + | + | + | + | – | 2.5-5.5 | |
| Deder | EHHFR3C | + | + | + | + | + | – | 2.5-5.5 |
| EHHFR3D | + | + | + | + | + | – | 2.5-5.5 | |
| EHHFR4A | + | + | + | + | + | – | 2.5-5.5 | |
| EHHFR4B | – | + | + | + | + | – | 3-5.5 | |
| EHHFR4C | – | + | + | + | + | + | 3-6 | |
| EHHFR4D | + | + | + | + | + | + | 2.5-6 | |
| EHHFR5A | – | + | + | + | – | – | 3-5 | |
| EHHFR5B | – | + | + | + | – | – | 3-5 | |
| EHHFR5C | – | + | + | + | – | – | 3-5 | |
| EHHFR5D | – | + | + | + | – | – | 3-5 | |
| EHHFR6A | – | + | + | + | + | + | 3-6 | |
| Kurfa Chele | EHHFR6B | + | + | + | + | + | + | 2.5-6 |
| EHHFR6C | + | + | + | + | + | – | 2.5-5.5 | |
| EHHFR6D | + | + | + | + | + | – | 2.5-5.5 | |
| EHHFR7A | + | + | + | + | + | – | 2.5-5.5 | |
| EHHFR7B | + | + | + | + | + | – | 2.5-5.5 | |
| EHHFR7C | + | + | + | + | + | – | 2.5-5.5 | |
| EHHFR7D | + | + | + | + | + | – | 2.5-5.5 | |
| EHHFR8A | + | + | + | + | + | – | 2.5-5.5 | |
| EHHFR8B | – | + | + | + | + | – | 3-5.5 | |
| EHHFR8C | – | + | + | + | – | – | 3-5 | |
| % of tolerant isolates | 67.7 | 100 | 100 | 100 | 83.9 | 12.9 | ||
The tolerance to pH changes varied amongst the tested isolates (Table 2). In this study, growth was detected from pH 4.5-8. All of the isolates were found to grow in the range of pH 5.5-7.5. Nine point seven percent of the isolates were adapted to grow at pH 4.5, whereas 87% of the isolates managed to grow at pH 8. Isolates EHHFR 4A from Deder and EHHFR6B from Kurfa Chele were managed to grow at all the tested pH values. All isolates except EHHFR (4A, 6B, 6D) were failed to grow at pH 4.5. Similarly, Bordeleau and Prevost (1994) showed that fast-growing rhizobia are commonly susceptible to low pH but grow best nearly at neutral to basic pH. In line with this, Alemayehu Workalemau (2006), Esubalew Sintie (2010) and other similar domestic researchers revealed that acid-producing rhizobia are poor intolerance to low soil pH conditions.
Table 2: Tolerance of the Isolates to the Different pH Level.
| Sampling woredas (Districts) |
Isolates | pH | Tolerance range | |||||||
| 4.5 | 5 | 5.5 | 6 | 6.5 | 7 | 7.5 | 8 | |||
| Bedeno | EHHFR 1A | – | + | + | + | + | + | + | – | 5-7.5 |
| EHHFR 1B | – | – | + | + | + | + | + | – | 5.5-7.5 | |
| EHHFR1C | – | + | + | + | + | + | + | + | 5-8 | |
| EHHFR1D | – | + | + | + | + | + | + | + | 5-8 | |
| EHHFR2A | – | _ | + | + | + | + | + | + | 5.5-8 | |
| EHHFR2B | – | + | + | + | + | + | + | + | 5-8 | |
| EHHFR2C | – | _ | + | + | + | + | + | + | 5.5-8 | |
| EHHFR2D | – | + | + | + | + | + | + | + | 5-8 | |
| EHHFR3A | – | + | + | + | + | + | + | + | 5-8 | |
| EHHFR3B | – | + | + | + | + | + | + | + | 5-8 | |
| Deder | EHHFR3C | – | + | + | + | + | + | + | + | 5-8 |
| EHHFR3D | – | _ | + | + | + | + | + | + | 5.5-8 | |
| EHHFR4A | + | + | + | + | + | + | + | + | 4.5-8 | |
| EHHFR4B | – | + | + | + | + | + | + | + | 5-8 | |
| EHHFR4C | – | + | + | + | + | + | + | _ | 5-7.5 | |
| EHHFR4D | – | + | + | + | + | + | + | + | 5-8 | |
| EHHFR5A | – | + | + | + | + | + | + | + | 5-8 | |
| EHHFR5B | – | + | + | + | + | + | + | + | 5-8 | |
| EHHFR5C | – | – | + | + | + | + | + | + | 5.5-8 | |
| EHHFR5D | – | + | + | + | + | + | + | + | 5-8 | |
| EHHFR6A | – | + | + | + | + | + | + | + | 5-8 | |
| Kurfa Chele | EHHFR6B | + | + | + | + | + | + | + | + | 4.5-8 |
| EHHFR6C | – | + | + | + | + | + | + | + | 5-8 | |
| EHHFR6D | + | + | + | + | + | + | + | – | 4.5-7.5 | |
| EHHFR7A | – | + | + | + | + | + | + | + | 5-8 | |
| EHHFR7B | – | + | + | + | + | + | + | + | 5-8 | |
| EHHFR7C | – | – | + | + | + | + | + | + | 5.5-8 | |
| EHHFR7D | – | + | + | + | + | + | + | + | 5-8 | |
| EHHFR8A | – | – | + | + | + | + | + | + | 5.5-8 | |
| EHHFR8B | – | + | + | + | + | + | + | + | 5-8 | |
| EHHFR8C | – | + | + | + | + | + | + | + | 5-8 | |
| % of tolerant isolates | 9.7 | 100 | 100 | 100 | 100 | 100 | 100 | 87 | ||
Key: (+) = Presence of growth; (-) = Absence of growth
Determination of the Symbiotic Efficiency of Faba Bean Rhizobia under Sterilized Sand in a Pot Experiment
The inoculated plants showed significant variations (p< 0.05) in nodule number, nodule dry weight, shoot dry weight, and plant total nitrogen (Table 3). Each of the presumptive rhizobial isolates was tested for their ability to root nodulation and their symbiotic efficiency on faba bean‘‘Motie variety’’ in sterile pots using sterilized sand culture in the main campus of Haramaya University greenhouse. In this study, only thirty-one of the isolates were able to induce nodulation on faba bean (Vicia faba L.) and were subsequently authenticated as true faba bean nodulating Rhizobium isolates (Somasegaran and Hoben, 1994). In line with this, Argaw (2012) reported that nearly 82%of his rhizobial isolates were successful in nodulating faba bean plants in central Ethiopian soil. In contrary to this, Menalku et al. (2009) reported that all of his isolates were successful in inducing nodules on faba bean plant in the eastern and western Hararghe highlands soil of Ethiopia.
Table 3: The Symbiotic Efficiency of Faba Bean (Vicia faba L.) Rhizobial Isolates and their Ability to Produce Root Nodules on Sterilized Sand.
| Sampling woredas (Districts) |
Treatment | Nodule number plant-1 | Nodule dry weight plant-1 | Shoot dry weight plant-1 | Plant total nitrogen (%) | Symbiotic effectiveness (%) | Effectiveness |
| Bedeno | EHHFR 1A | 257.27C | 0.49F | 1.23L | 4.03HIJKL | 53 | E |
| EHHFR 1B | 317.13B | 0.76D | 2.3E | 4.7DEFG | 99 | HE | |
| EHHFR1C | 167.00GH | 1.16A | 2.4CDE | 2.57OP | 103 | HE | |
| EHHFR1D | 89.667MN | 0.71D | 1.65IJ | 4.08GHIJK | 71 | E | |
| EHHFR2A | 207.27DEF | 1.10AB | 2.32DE | 4.27EFGHIJK | 99 | HE | |
| EHHFR2B | 196.00EFG | 0.48F | 1.66IJ | 4.45DEFGHI | 71 | E | |
| EHHFR2C | 220.4DE | 0.50F | 2.41CDE | 3.77JKLM | 103 | HE | |
| EHHFR2D | 295.93B | 0.58EF | 1.54JK | 3.92IJKLM | 66 | E | |
| EHHFR3A | 148.4HIJ | 0.55EF | 1.84GH | 5.35BC | 79 | E | |
| EHHFR3B | 133.93IJK | 0.763D | 1.92FG | 4.53DEFGHI | 82 | HE | |
| Deder | EHHFR3C | 150.07HIJ | 1.04ABC | 1.99FG | 2.3P | 85 | HE |
| EHHFR3D | 226.2D | 0.913C | 2.49BCD | 3.77JKLM | 107 | HE | |
| EHHFR4A | 352.07A | 0.99BC | 2.66B | 6.20A | 114 | HE | |
| EHHFR4B | 228.13CD | 0.94C | 1.66IJ | 4.13GHIJK | 71 | E | |
| EHHFR4C | 123.6IJKL | 0.96C | 2.46CDE | 4.86CDE | 105 | HE | |
| EHHFR4D | 41.733O | 0.65DE | 2.5BC | 4.08HIJK | 107 | HE | |
| EHHFR5A | 61.4NO | 0.65DE | 1.86GH | 2.65OP | 80 | E | |
| EHHFR5B | 121.33JKL | 0.12HI | 1.73HI | 3.05NO | 74 | E | |
| EHHFR5C | 96LM | 0.120GHI | 1.46K | 3.43LMN | 63 | E | |
| EHHFR5D | 185FG | 0.14GH | 1.96FG | 4.82CDEF | 84 | HE | |
| EHHFR6A | 152HI | 0.21GH | 3.34A | 5.81AB | 143 | HE | |
| Kurfa Chele | EHHFR6B | 121.87JKL | 0.18GH | 1.13LM | 4.54DEFGH | 49 | LI |
| EHHFR6C | 132.01IJK | 0.14GH | 1.03M | 0.48Q | 44 | LI | |
| EHHFR6D | 123.17IJKL | 0.15GH | 1.03M | 3.96HIJKLM | 44 | LI | |
| EHHFR7A | 112.5KLM | 0.15GH | 2.05F | 4.21FGHIJK | 88 | HE | |
| EHHFR7B | 128.93IJK | 0.14GH | 1.92FG | 3.44LMN | 82 | HE | |
| EHHFR7C | 129.02IJK | 0.18GH | 1.17LM | 3.41MN | 50 | E | |
| EHHFR7D | 111.07KLM | 0.11HI | 2.3LE | 4.32EFGHIJ | 99 | HE | |
| EHHFR8A | 124.03IJKL | 0.24G | 1.23L | 5.02CD | 53 | E | |
| EHHFR8B | 117.05KLM | 0.17GH | 1.09LM | 6A | 47 | LI | |
| EHHFR8C | 147.75HIJ | 0.19GH | 1.99FG | 3.67KLMN | 86 | HE | |
| Control(+) | 0P | 0I | 2.33CDE | 2.45OP | – | – | |
| Control(-) | 0P | 0I | 1.07LM | 2.03P | – | – | |
| Mean | 152.06 | 0.47 | 1.87 | 3.95 | |||
| CV | 12.12 | 17.0 | 6.0 | 10 | |||
| LCD(P<0.05) | 30.1 | 0.13 | 0.18 | 0.62 | |||
Key: Numbers in the same column followed by the same letters are not significantly different at p<0.05(Fisher’s LSD). SE= Symbiotic Effectiveness; I= Ineffective; E= Effective and HE= Highly Effective; LSD= list significant difference. % SE= >80% is highly effective, 50-80 % is effective, and < 35% is ineffective.
Visual observation of the outward appearances of inoculated plants had also shown that they were visibly different from the negative control. The least number of nodules was recorded for the plant inoculated with isolate EHHFR4D (42/plant) and the highest was for the plant inoculated with isolate EHHFR4A (352/plant)both from Deder woreda. The average nodule number produced by faba bean plants in this study (152 nodules/plant) was more than those obtained by Zerihun (2006), Getaneh (2008) and Menalku et al. (2009), which were 124, 87, and 128 nodules per plant, respectively. Regarding nodule dry weight, 0.11 g plant-1) and 1.16 g plant-1 were the smallest and highest nodule dry weight recorded for plants inoculated with isolates EHHFR (7D, 5B) and EHHFR1C, respectively. The average nodule dry weight produced by faba bean plant in this study (0.47 g plant-1) was by far greater than the observation made by Zerihun (2006), Getaneh (2008), Menalku et al. (2009) and Argaw (2012), who reported nodule dry weights of 0.07, 0.075, 0.084 and 0.145 g plant-1, respectively. The above difference in nodule dry weights could be credited to the difference in the efficiency of nodules in fixing nitrogen and the host species since isolates from different agro-ecologies were tested on different host varieties as was explained similarly by Endalkachew (2007).
The highest (3.34 g plant-1) and the least (1.03 g plant-1) shoot dry matter accumulations were recorded from plants inoculated with isolate EHHFR6A and isolate EHHFR6C & 6D, respectively. The average shoot dry weight produced by faba bean plant in this study (1.87 g plant-1) was less than the average value obtained by Argaw (2012), which was 2.086 g plant-1 but higher than the average values obtained by Getaneh (2008), Menalku et al. (2009) and Zerihun (2006), who reported shoot dry weight of 1.21, 1.39 and 1.63 g plant-1, respectively. According to Somasegaran and Hoben (1994) and Peoples et al. (1992), shoot, dry matter is a good indicator of the relative symbiotic efficiency of the isolates, and there exists a positive correlation between the nitrogen-fixing capacity of legumes and their shoot dry matter accumulation. Thus, the highest shoot dry weight value mentioned in this study which was (65%) higher than the shoot dry weight value of the negative control indicates the presence of symbiotically efficient rhizobia in this part of Ethiopia.
The highest (6.20%) and the least (2.3%) plant total nitrogen buildup were recorded from plants inoculated with isolate EHHFR4A and isolate EHHFR3C, respectively. The average plant total nitrogen buildup by faba bean plant in this study was 3.95%. This result was almost similar to the result indicated by Argaw (2012, which was 4.3%.
Plants inoculated with isolates EHHFR4A, EHHFR1C, EHHFR6A and EHHFR4A showed significantly (p<0.05) higher nodule number, nodule dry weight, shoot dry weight, and plant total nitrogen than any of the other inoculated plants respectively.
As correlation data among variables on the sand experiment depicted plant total nitrogen, symbiotic effectiveness, and nodule dry weight was associated positively and significantly (p<0.001) with nodule number with (r= 0.38, 0.4, and 0.48), respectively. Similar to this, Agraw (2012) also reported that there was a positive correlation between nodule number and nodule dry weight at (r= 0.7142, p<0.001). Shoot dry weight and symbiotic effectiveness were associated positively and significantly (p<0.001) with nodule dry weight with(r=0.39 and 0.5), respectively. In line with this, Menalku et al., (2009)and Argaw (2012) also reported a positive correlation of (r= 0.49, p <0.01) and (r= 0.49, p< 0.001) for the association of nodule dry weight with shoot dry weight, respectively. Plant total nitrogen and symbiotic effectiveness were associated positively and significantly(r=0.24, p<0.01) and (r=0.7, p<0.001) with shoot dry weight. Symbiotic effectiveness was associated positively and significantly (r=0.42, P<0.001) with plant total nitrogen (Appendix Table 1).
The significant positive correlation of nodule number/nodule dry weight, nodule dry weight/ shoot dry weight, plant total nitrogen/ shoot dry weight, and symbiotic effectiveness/ shoot dry weight validate the N fixation efficiency of isolates and the importance of these parameters to determine symbiotic effectiveness of faba bean rhizobia (Fening and Danso, 2002; He et al., 2011; Denton et al, 2000).
Concerning the relative symbiotic effectiveness about (52%, 35%, and 13%) of the isolates were found to be highly effective, effective, and lowly-effective respectively (Table 3). Considering the site of location, 50% isolates from Bedeno, 63.34% from Deder, and 40% from Kurfa Chele woredas were highly effective. 50% of the isolates from Bedeno, 36.36% of the isolates from Deder, and 20% of the isolates from Kurfa Chele woredas were effective. As indicated in Table 3, the highest scores of effectiveness in symbiotic nitrogen fixation were displayed by the following isolates from the highest score, which was 143% to the lowest score (44%) in decreasing order; EHHFR6A, EHHFR4A, EHHFR 3D, EHHFR4D, and EHHFR (4C, 1C, 2C, 1B, 2A, 7D, 7A, 8C, 3C, 5D, 3B, 7B, 5A, 3A, 5B, 1D, 2B, 4B, 2D, 5C, 1A, 8A, 7C, 6B, 8B, 6C, 6D). In this study, 87.1% of the isolates were categorized into effective and highly effective groups.
In similar works, Zerihun (2006), Getaneh (2008) and Argaw (2012) reported that more effective isolates were obtained from a wide range of geographical locations on Ethiopian soil. These research results confidently indicate the survival and abundance of effective faba bean nodulating rhizobia in our soil.
Determination of Symbiotic Efficiency of Selected Faba Bean Nodulating Rhizobia on Unsterilized Soil
From the sand culture, EHHFR (1C, 2C) from Bedeno and EHHFR (3D, 4A, 4C, 4D,6A) from Deder were the seven highly effective isolates selected as inoculants for Faba bean plant and tested on unsterilized soil under greenhouse condition at Haramaya University main campus. In this study the different rhizobial inoculants showed variation in nodule number, nodule dry weight, shoot dry weight, N percent, and N contents on the inoculated faba bean plants (Table 5). In line with this, Amarger et al.(1996) reported that symbiotic effectiveness of rhizobial isolates showed variation in nodulation, shoot dry weight, nodule dry weight, and total nitrogen of legumes as it could be influenced by soil aeration, inoculums size, and viability, soil nutrient level, soil pH, temperature and absence or presence of native rhizobia in the soil.
Table 4: Rating of the Effectiveness of Isolates by Sampling Site (Woreda)
| Sampling woredas (Districts) |
%HE | %E | %LE | %Total | Highly isolates |
Effective Isolates |
Lowly effective Isolates |
| Bedeno | 50% | 50% | 0 | 100 | 1B,1C,2A,2C,3B, | 1A,1D,2B,2D, 3A | – |
| Deder | 63.64% | 36.36% | 0 | 100 | 3C,3D,4A,4C,4D,5D,6A | 4B,5A,5B,5C | – |
| Kurfa Chele | 40% | 20% | 40% | 100 | 7A,7B,7D, 8C | 7C, 8A | 6B,6C,6D,8B |
Key: %HE= Highly Effective, %E= Effective %LE= Lowly Effective
Table 5: The Symbiotic Efficiency of Selected Faba Bean (Vicia faba L.) Nodulating Rhizobial Isolates and their Ability to Produce Root Nodules on Unsterilized Soil.
| Sampling woredas (Districts) |
Isolates | Nodule number plant-1 | Nodule dry weight plant-1 (g) | Shoot dry weight plant-1 (g) | Plant total nitrogen (%) | N Content (g/pl) |
| Bedeno | EHHFR1C | 156.85a | 0.2938a | 7.446a | 3.6433b | 0.2623bc |
| EHHFR2C | 123.67b | 0.1175de | 6.2023bc | 4.0867b | 0.2671bc | |
| Deder | ECHFR3D | 72.31c | 0.1173de | 7.255ab | 5.2857a | 0.3806a |
| EHHFR4A | 84.77c | 0.1566bc | 6.348abc | 4.1433b | 0.2709b | |
| EHHFR4C | 132.82ab | 0.1321cd | 7.4367a | 4.164b | 0.2998b | |
| EHHFR4D | 120.52b | 0.1779b | 5.2483cd | 3.8567b | 0.2777b | |
| EHHFR6A | 114.48b | 0.1345cd | 6.2117bc | 3.9483b | 0.2843b | |
| Control(+) | 63.3c | 0.0917e | 7.3ab | 4.102b | 0.2953b | |
| Control(-) | 68.95c | 0.1145de | 4.694d | 2.9128c | 0.2097c | |
| Mean | 104.19 | 0.148 | 6.46 | 4.01 | 0.28 | |
| CV | 13.0 | 13.0 | 14.0 | 13.0 | 13.0 | |
| LCD(P<0.05) | 24.077 | 0.0332 | 1.1911 | 0.7277 | 0.0582 | |
Key: Numbers in the same column followed by the same letters are not significantly different at p<0.05(Fisher’s LSD). SE= Symbiotic Effectiveness; I= Ineffective; E= Effective and HE= Highly Effective; LSD= list significant difference. % SE= >80% is highly effective, 50-80 % is effective, and < 35% is ineffective.
Similarly, Giller (2001) also explained that the variation in nodulation, nodule dry weight, shoot dry weight, and percent of nitrogen in the soil cultures may be attributed to the difference of nitrogen in the soil, and additional nodulation by the native rhizobia of soils and other rhizosphere effects on plant growth.
EHHFR1C was the isolate that induced the highest nodule number (156.85 per plant) followed by isolates EHHFR4C with a nodule number of 132.82 per plant, respectively. The least number of nodules was induced by plants inoculated with isolates EHHFR3D and EHHFR4A with nodules number 72.31 per plant and 84.77 per plant, correspondingly. The average nodule number produced by faba bean plant on unsterilized soil in this study (104 nodules per plant) was higher than those obtained by Getaneh (2008), which was 87 nodules per plant but lower than those obtained by Zerihun (2006) and Menalku et al. (2009), which were 124 and 128 nodules per plant, respectively.
All isolates except EHHFR (3D&4A) showed significantly (p <0.05) higher nodule numbers than both positive and negative controls. Isolates EHHFR (1C & 4C) showed significantly (p<0.05) higher shoot dry weight than all other inoculated and non-inoculated plants. This study, (Appendix Table 3) showed that positive correlations were observed with respect to nodule number and nodule dry weight, shoot dry weight and plant total nitrogen, shoot dry weight and N content, plant total nitrogen and N content (r = 0.64, p<0.001), (r = 0.7, p<0.001), (r = 0.9, p<0.001) and (r = 0.65, p<0.001), respectively. In line with this, Menalku et al. (2009) observed a positive and highly significant correlation in N content with shoot dry weight and percent N (r = 0, 73 and 0, 81), respectively (p < 0,001).
Comparing the nodule number of the controls with the inoculated plants, the least nodule number for the inoculated plant (72.31 per plant) was greater than the nodule number of positive control by (14.23%), and the nodule number of negative control by 4.87%. Even comparing the nodule number of the positive control with the negative control, the negative control nodule number was greater than the nodule number of the positive control by 8.54 %. Possibly beside other several influencing factors, inhibitory effects of fertilizer; beyond 48 kg N ha− 1 and 45 kg P ha−1, and nitrogen treatment were responsible for the inadequate symbiosis between the positive control and the rhizobia in the soil (Giller, 2001; Sabry and Abdel‐Ghaffar, 2009; Ümmühan and Uyanoz, 2012).
In this study, 0.29 and 0.11 g plant-1 were the highest and the lowest nodule dry weight recorded by plants inoculated with isolate EHHFR1C and EHHFR3D, correspondingly. All isolates except EHHFR (2C, 3D) showed significantly (P < 0.05) higher nodule dry weight than the positive control. On the contrary, only EHHFR (1C, 4A, 4D) showed significantly (P < 0.05) higher nodule dry weight response than isolates EHHFR (2C, 3D, 4C, 6A) and the negative control. The highest nodule dry weight (0.086 g plant-1 which is documented by Menalku et al. (2009) is by far smaller than the highest nodule dry weight (0.294 g plant-1 of this study by 70.8%. The average nodule dry weight produced in this study was 0.148 g plant -1. This value was by far higher when compared to the mean value obtained by Menalku et al. (2009) in eastern and western Hararghe highlands soils (0.072 g plant-1), Zerihun (2006) in Ambagiorgis soils (0.032 g plant-1), and Getaneh (2008) in Sebeta (0.058 g plant-1), respectively.
EHHFR(1C&4C) were the isolates that scored the highest shoot dry weight (7.44 and 7.43 g plant-1) followed by isolate EHHFR3D with shoot dry weight of 7.2 g plant-1. The least shoot dry weight was 5.2 g plant-1 induced by isolate EHHFR4D. All isolates except EHHFR 4D showed significantly (p<0.05) higher shoot dry weights than the negative control. The average shoot dry weight scored in this study was 6.46 g plant-1. This value was 71.7%, 80.9% and 87.8% higher when compared to the mean value obtained by Menalku et al. (2009) in eastern and western Hararghe highlands soils (3.05 g plant-1), Zerihun (2006) in Ambagiorgis soils (2.74 g plant-1) and Getaneh (2008) in Sebeta (2.52 g plant-1, respectively.
Isolate EHHFR3D was the only isolate that showed significantly (<0.05) higher % N and N content than any of the inoculated, negative and positive controls (Table 5). In this study, 5.28% for a plant inoculated with isolate EHHFR3D and 3.64% for a plant inoculated with isolate EHHFR1C were the highest and the lowest record of % N, respectively. Here the % N of the negative control (2.9%) decreased from the lowest value % N of this study (3.64%) by 22.29%. The average % N scored in this study (4.01%) was 14.94% higher than the average value obtained by Menalku et al. (2009) in eastern and western Hararghe highlands soils (3.53%). In this regard, opposite of Zerihun (2006), Getaneh (2008) and Menalku et al. (2009) observed a significant (p < 0.05) difference between the negative control and most of his inoculated isolates. However, he was unable to observe any isolates that showed significantly (p<0.05) higher % N over the positive control. Regarding N content, 0.38 g plant-1 for a plant inoculated with isolate EHHFR3D and 0.262 g plant-1 for a plant inoculated with isolate EHHFR1C were the highest and the lowest record for this study. The average N content of this study was 0.28 g plant -1. This value was 87.2% higher when compared to the mean value obtained by Menalku et al. (2009) in eastern and western Hararghe highlands soils (0.11/plant).
Summary and Conclusion
Among the 40 presumptively identified rhizobia isolates, only 31 (77.5%) are authenticated as true faba bean nodulating rhizobia. In the sand experiment, the maximum nodule number (352.07 per plant) and the minimum number of nodules (41.733 per plant) were scored from plants that were inoculated by EHHFR4A and EHHFR4D isolates, respectively. The highest and lowest dry weight of shoots was recorded for plants inoculated with EHHFR 1C (1.16 g per plant) and EHHFR (5B, 7D) (0.11 g per plant), respectively. Plants inoculated with isolate EHHFR4A showed significantly (p<0.05) higher nodule number, and plant total nitrogen than any of the other plants.EHHFR1C showed significantly (p<0.05) higher nodule dry weight than any of the other plants. EHHFR 6A showed significantly (p<0.05) higher shoot dry weight than any of the other plants including the positive control. Depending on their shoot dry weight about the N-fertilized control plant, the isolates displayed variation in effectiveness ranging from 44% to 143%.
In this study, isolates were also found to show diversity in their response to different NaCl concentrations and different pH values. Isolates were very sensitive to concentrations of NaCl beyond <9%. Correlation response among variables in the sand experiment for faba bean rhizobia confirmed that nodule dry weight was associated positively and significantly (r = 0.494, p<0.05) with shoot dry weight while shoot dry weight was associated positively and significantly(r=0.41, p<0.05) with plant total nitrogen. Concerning the relative symbiotic effectiveness about 16 (52%), 11 (35%) and 4 (13%) of the isolates were found to be highly effective, effective, and lowly effective, respectively.
On an unsterilized soil experiment, all isolates except EHHFR (3D&4A) showed significantly (p <0.05) higher nodule numbers than both positive and negative controls. Isolates EHHFR (1C & 4C) showed significantly (p<0.05) higher shoot dry weight than other plants. EHHFR (1C&4C) were the isolates that induced the highest shoot dry weight (7.44 and 7.43 g plant-1) followed by isolate EHHFR 3D with shoot dry weight of 7.2 g plant-1. The least shoot dry weight was 5.2 g plant-1 induced by isolate EHHFR 4D. Positive correlations were observed concerning shoot dry weight and dry weight of nodules (r = 0.7, p<0.05). Results of this study make known the abundance and existence of effective faba bean rhizobial isolates in these specific areas of eastern Hararghe highlands of Ethiopia. Thus, based on their symbiotic efficiency at the greenhouse level and relative tolerance to extreme conditions these faba bean nodulating rhizobia isolates were recommended to be used as candidates for the future development of faba bean rhizobial inoculants after being tested on field conditions.
Funding Source
The author(s) received no financial support for the publication of this article.
Conflict of Interest
No conflict of interest.
References
- Alemayehu Workalemahu. Symbiotic and phenotypic characterization of Common bean nodulating rhizobia from some area of southern Ethiopia.2006; M. Sc. (Biology) thesis submitted to Addis Ababa University, Ethiopia.
- Amarger N., Laguerre G., Mavingue P., charnay M.P., Louvrier S., Mazurier and Rigottier-gois .Application to Rhizobium Leguminosarum and its different biovars.Appl. Environ Microbiol. 1996; 62:2029-2036.
CrossRef - Argaw A. Characterization of Symbiotic effectiveness of Rhizobia Nodulating Faba bean (Viciae faba) Isolated from central Ethiopia. Research Journal of Microbiology. 2012; 7(6):280-296.
CrossRef - Aynabeba A, Asfaw H, Fassil and Endeshaw. Studies of Rhizebittm inoculation and fertilizer treatment on growth and production of faba bean (Vida faba L ) In some ‘Yield-Depleted’ and ‘Yield-Sustained’ regions of Semen Shoa. SINET: Ethiop. J. Sci.2001; 24(2):197-211.
CrossRef - Beck D.P., Materon L.A and Afandi F. Practical Rhizobium-legume technology manual, Technical Manua.1993; l No: 19. ICARDA, Aleppo, Syria.
- Belay S.Wortmann C.W.S and Hoogenboom G. Haricot bean agro ecology in Ethiopia: definition using agro-climatic and crop growth simulation models. African Crop Science Journal.1998; 6: 9-18.
CrossRef - Bordeleau L.M and Prevost D. Nodulation and nitrogen fixation in extreme environments. Plant Soil.1994; 161:115-124.
CrossRef - Agricultural Sample Survey 2017/2018 (2010 E.C.): Report on Area and Production of Crops (Private Peasant Holdings, Meher Season). Central Statistical Agency Ethiopia, Addis Ababa, Ethiopia. Statistical bulletin.1018; 586. pp.57.
- Agricultural Sample Survey 2019/2020 (2012 E.C.): Report on Area and Production of Crops (Private Peasant Holdings, Meher Season). Central Statistical Agency Ethiopia, Addis Ababa, Ethiopia. Statistical bulletin. 2010/20; 587. pp.11
- Denton M.D., Coventry D.R., Bellotti and Howieson.Distribution, abundance, and symbiotic effectiveness of Rhizobium leguminosarum bv. trifolii from alkaline pasture soils in South Australia. Australia J. Experi. Agric.2000; 40:25-35.
CrossRef - Endalkachew Wolde-Meskel. Genetic diversity of rhizobia in Ethiopian soils: their potential to enhance biological N fixation (BNF) and soil fertility for sustainable agriculture. Ethiop. J. Biol. Sci.2007; 69( I ): 77-95.
- Esubalew Sintie . The symbiotic effectiveness of Lupin (Lupinus albus L.)- Noudulating Rhizobia from Western Gojam, Amhara Regional State, Ethiopia May 2010, MSc Thesis, Haramaya University.
- Food and Agriculture Organization at www.fao.org.2010.
- Food and agriculture organization of the United Nations Rome.2016.
- FAOSTAT. FAOSTAT Database. Rome, Italy: FAO. 2017; Retrieved on April.20, 2018 from
http://www.fao.org/faostat/en/#data/QC - Fening J.O. and Danso S.K.A. Variation in symbiotic effectiveness of cowpea bradyrhiobia indigenous to Ghanaian soil. Applied Soil Ecol.2008; 21:23-29.
CrossRef - Getaneh T. Symbiotic and phenotypic diversity of rhizobial isolates nodulating faba bean {Vicia faba 1.) from Western Shoa and Western Hararghe. Ethiopia.2008; MSc Thesis. School of Graduate Studies. Addis Ababa University.
- Giller K.E. Nitrogen fixation in tropical cropping systems. Second Edition. CABI Publishing, Wallingford. 2001;UK.
CrossRef - Gupta K.P.Soil, Plant, and Water and Fertilizer Analysis.AGROBIOS (India).2000; PP.234-245.
- He Y.L., Duo H., Zhang and Huang G. Symbiotic effectiveness of pea-rhizobia associations and the implications for farming systems in the Western Loess Piateau, China.African J. Biotech.2011; 10: S540-5548.
- Hungaria M. and Vergas M.A.T. Environmental factors affecting N2 fixation in grain legumes in tropics, with an emphasis on Brazil. Field crops research. 2000; 65: 151-164.
CrossRef - Johnston A.W.B. and Beringer J.E. Pe root nodules containing more than one Rhizobi umspecies. 1976; Nature, 260: 502-504.
CrossRef - Lupwayi N. and Haque I. Legume-Rhizobium Technology Manual. Environmental Sciences Division International Livestock Center for Africa. 1994; Addis Ababa, Ethiopia, pp.1-93.
- Menalku A.H., Gebrekidan F., Assefa. Symbiotic effectiveness and characterization of Rhizobium strain of Faba bean ( Viciae faba L.) collected from Eastern and Western Hararghe Highlands, Ethiopia. Europ. J.Amer.studies. 2009;11:223-244.
- Mitiku G. and Mnalku A. Faba bean (Vicia faba L.) yield and yield components as influenced by inoculation with indigenous rhizobial isolates under acidic soil condition of the Central Highlands of Ethiopia. Ethiop. J. Agric. Sci. 2019; 29(3):49-61.
- Ogutcu H., Omer F., Algur Elkoca and Kantar. The Determination of Symbiotic Effectiveness of Rhizobium Strains Isolated from Wild Chickpeas Collected from High Altitudes in Erzurum Turk J Agric For. 2008; 32:241-248.
- Ahmed Sabry and Ghaffar. Factors affecting nitrogen fixation and yield of faba bean (Vicia faba) under Egyptian field conditions. 2009; A review.
- Somasegaran and Hoben. Hand book for Rhizobia. Springer- Verlang, New York. 1994;1-138 pp.
CrossRef - Ümmühan and Refik. Effectiveness of native Rhizobium on nodulation and growth properties of dry bean (Phaseolus vulgaris L.).2012; Department of Soil Science and Plant Nutrition, Faculty of Agriculture, Selcuk University, 42075 Konya, Turkey.
CrossRef - Vincent J.M. A Manual for the Practical Study of Root Nodule Bacteria.1970; Oxford: Blackwell Scientific.
- Zerihun B. Symbiotic and phenotypic diversity of Rhizobium leguminosaram bv. Viciae Isolates (Vicia faba) from Northern Gondar, Ethiopia. 2006; An MSc Thesis, School of graduate studies, Addis Ababa University.
Appendices
Appendix Table 1: Correlation Coefficient Parameters on Sand Experiment for Rhizobium.
| NN | NDW(g) | SDW(g) | PTN (%) | (SE %) | |
| NN | 1 | ||||
| NDW(g) | 0.4855*** | 1 | |||
| SDW(g) | 0.1851ns | 0.3987*** | 1 | ||
| PTN (%) | 0.3831*** | 0.1306ns | 0.2548* | 1 | |
| SE (%) | 0.4485*** | 0.5177*** | 0.7725*** | 0.4226*** | 1 |
*, ***= Significant at p< 0.05 and p< 0.001, respectively, ns= Non significant, NN=Nodule number, NDW= Nodule dry weight (g per plant), SDW=Shoot dry weight (g per plant), PTN= Plant total nitrogen (%), SE= Symbiotic effectiveness (%)
Appendix Table 2: ANOVA for Nodulation Parameters on Sand Experiment for Rhizobium.
| Source of variation | Degree of freedom | Nodule Number | Nodule dry weight (g plant-1) | Shoot dry weight (g plant-1) |
Plant total nitrogen (%) |
|
||||
| Mean square | F-value | Mean square | F-value | Mean square | F-value | Mean square | F-value | F-value | ||
| Treatment | 32 | 19267.7 | 57.54 *** | 0.40 | 65.94 *** | 0.96 | 82.76*** | 4.26 | 29.93*** | 19.85* |
| Error | 66 | 334.84 | 0.006 | 0.012 | 0.14 | |||||
| Corrected Total | 98 | |||||||||
| CV (%) | 12 | 16.6 | 5.7 | 9.5 | ||||||
ns = Non-significant; *** = Significant at P < 0.001, CV= Coefficient of variation.
Appendix Table 3: Correlation Coefficient Parameters on Unsterilized Soil Experiment for Rhizobium.
| NN | NDW(g) | SDW(g) | PTN (%) | N-content (g plant-1) | |
| NN | 1 | ||||
| NDW(g) | 0.6454*** | 1 | |||
| SDW(g) | -0.114ns | -0.2488ns | 1 | ||
| PTN (%) | 0.1654ns | 0.0983ns | 0.7063*** | 1 | |
| N-content(g/pl) | -0.1135ns | -0.2238ns | 0.9148*** | 0.6503*** | 1 |
***= Significant at p<0.001, respectively, ns= Non significant, NN=Nodule number, NDW= Nodule dry weight (g per plant), SDW=Shoot dry weight (g per plant), PTN= Plant total nitrogen (%), N= Nitrogen content.
Appendix Table 4: ANOVA for Nodulation Parameters on Soil Experiment for Rhizobium.
| Source of variation | Degree of freedom | Nodule Number | Nodule dry weight (g plant-1) |
Shoot dry weight (g plant-1) |
Plant total nitrogen (%) | N-content (g plant-1) | |||||
| Mean square | F-value | Mean square | F-value | Mean square | F-value | Mean square | F-value | Mean square | F-value | ||
| Treatment | 8 | 3244.47 | 16.7*** | 0.01 | 28.8*** | 2.99 | 3.7* | 1.14 | 4.38** | 0.006 | 4.31** |
| Error | 18 | 192.32 | 0.0004 | 0.82 | 0.26 | 0.0014 | |||||
| Corrected Total | 26 | ||||||||||
| CV (%) | 13 | 13 | 13.9 | 12.7 | 13 | ||||||
*, **, ***= Significant at p< 0.0, at p<0.01and at p<0.001, respectively, ns= Non-significant, CV= Coefficient of variation.


